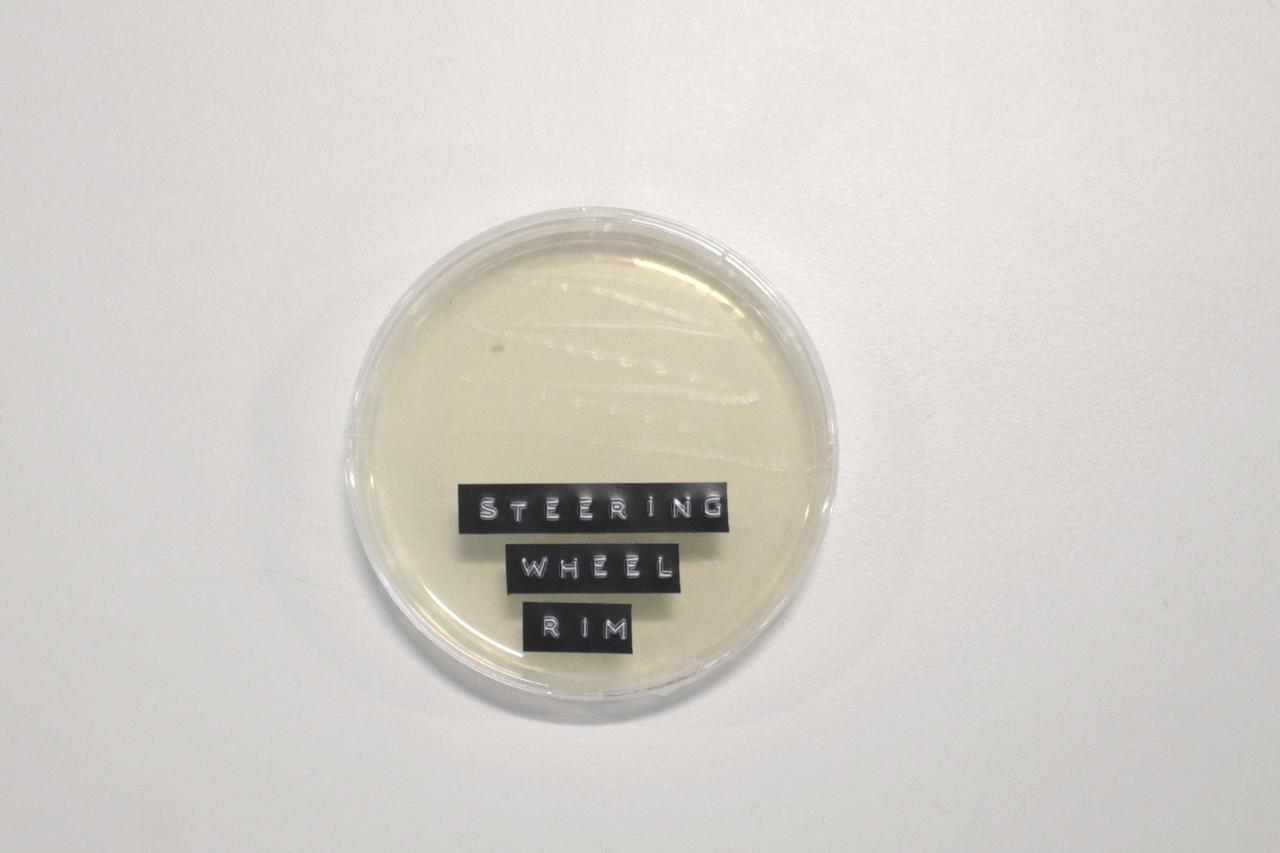
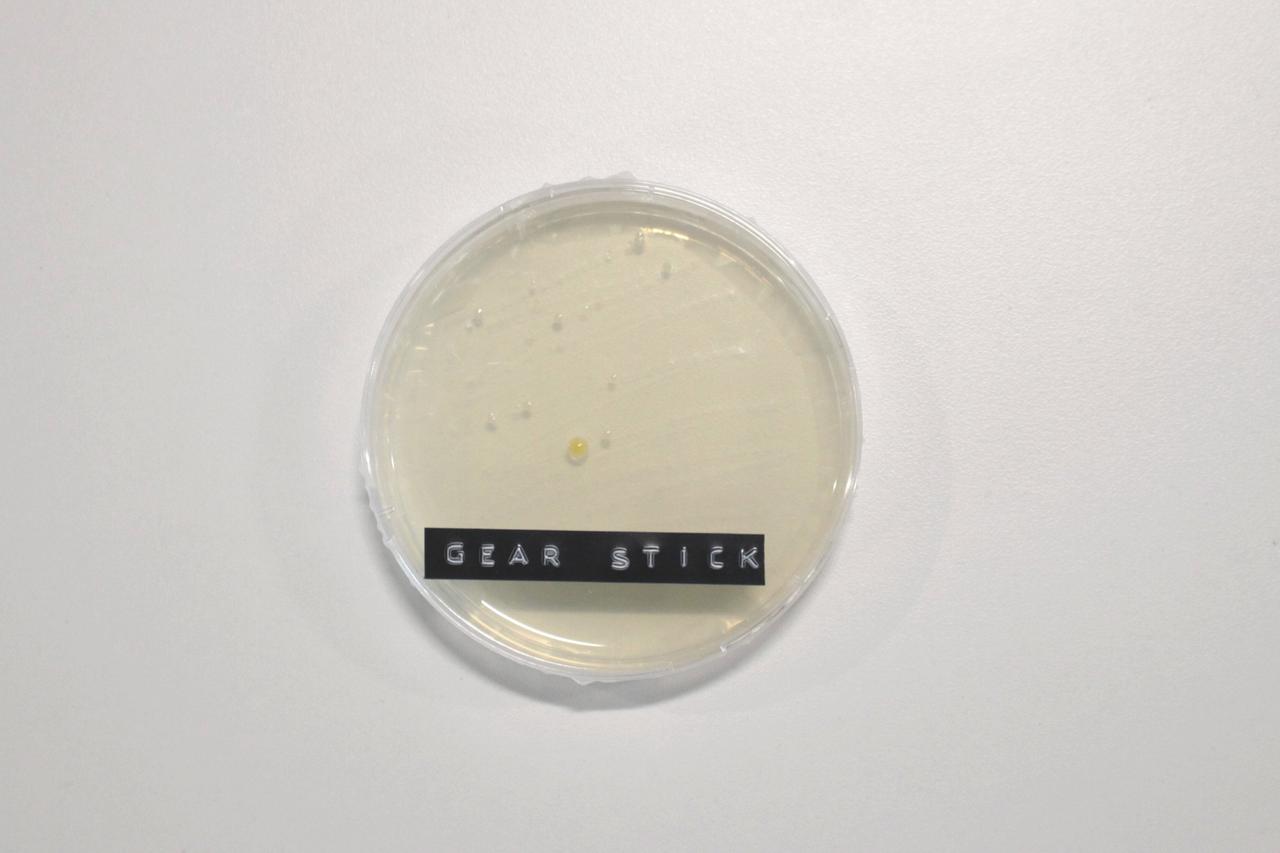

Did you know that your car could be the perfect breeding ground for germs? This is according to our latest research project - read on to find out more.
Are you guilty of ignoring a grubby car interior as long as the outside is sparkling clean? If so, have you ever thought about the germs that might be lingering in your vehicle? To see exactly what this might look like, Motorpoint conducted some research into what drivers’ car cleaning habits look like, as well as running some practical bacteria tests.
Our Survey
The team here at Motorpoint recently polled 1050 drivers to get a clearer picture of their car cleaning habits, and found that, on average, Brits clean the outside of our cars eight times a year (once every six weeks) and the insides slightly more at 9.6 times per year (or every five weeks).
Shockingly though almost 1 in 5 (18%) of drivers only clean the inside of their car three times a year or fewer, and almost 1 in 10 (9%) cleaned the interior just twice a year or less.
And, when it came to opinions on frequency of car cleaning, there was something of a gender split – men were more likely to focus on a gleaming exterior, whereas women were less willing to sitting in a grubby interior.
However, considering that 94% of UK drivers have consumed food or drink in their car before, and 58% of people admit that they have also had pets travelling with them, these numbers could be considered as a relatively low frequency for the potential demand.
Our Germ Testing Experiment
To test what the possible grubbiness looks like under the microscope, we borrowed a vehicle that belonged to a “typical driver” from our survey results (a pet owner who regularly ate or drank in their vehicle).
First, we gathered our testing kit equipment - sterilised cotton swabs and labelled agar petri dishes - and then meticulously swabbed each of the areas such as seatbelts and gearsticks, being careful to seal them quickly as not to cross-contaminate any samples.


Once prepped, we then swabbed 20 different areas of the car to get a range of samples. The areas were selected based on survey responses of which areas inside a car people thought would be the dirtiest, and included:
• Steering wheel - rim
• Steering wheel - horn
• Gear stick
• Handbrake
• Indicator lever
• Rear view mirror
• Radio volume button
• Internal door handle – drivers side
• Cup holder
• Dashboard
• Boot
• Driver seat
• Driver footwell
• Driver seat belt strap
• Driver seat belt buckle
• Driver seat belt button
• Back seat
• Back seat footwell
• Passenger seat
• Passenger footwell
As instructed, we then left the dishes in an open box in a warm place for five days and left the bacteria to thrive. Read on to see what we found…
The Results
We checked on the samples after five days, and the results were eye-opening. From all of our samples, the three items with the most visible bacteria were:

- The boot had collected the most visible germs and bacteria out of all the items. The car owner regularly transported their two pet dogs in the boot, indicating that our four-legged friends are partly to blame for bringing germs into our vehicles.

2. This was followed by the driver footwell, which makes sense as one of the most commonly used areas of the vehicle.


3. This was followed by the seatbelt button and the handbrake (see above), both of which are subject to a lot of touching.
At the other end of the spectrum, the three cleanest items were the rear-view mirror, steering wheel rim, and the gear stick. As you can see from the petri dishes below, there are very little germs collated – which is surprising despite being tactile areas of a car.



What Did We Learn?
So, when you’re letting your dog jump into the back seat, or you’re munching on a snack in the driver’s seat, take a moment to think about how many germs might be getting spread around your car.
The findings revealed that our cars can be a breeding ground for bacteria, and so it pays to regularly clean them, both inside and out.
As Alison Weatherley, Head of Marketing at Motorpoint, explains: "The results definitely revealed that maybe we need to clean our cars a little more often that we currently think is acceptable. Many drivers eat or drink in their vehicle, as well as chauffeuring young children or pets, and these can also have an impact on dirtiness in cars. To avoid excessive grubbiness, we recommend that people action regular car cleaning – both inside and out!”